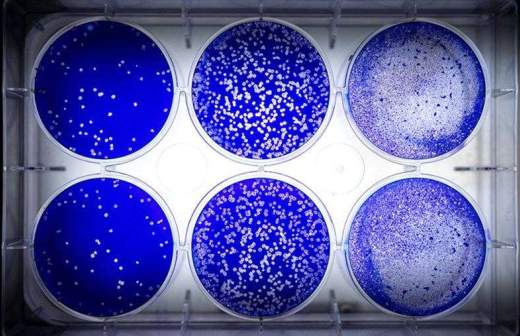

Украина замедленного действия
Современная Украина — по многим параметрам для своих соседей проблемное государство. Венгрия в прошлом году заблокировала совместное заявление комиссии Украина–НАТО и сняла свое вето только после того, как в него было внесено положение об обязательствах Киева по прекращению ущемления языковых и культурных прав венгерского меньшинства в этой стране. Польше в январе 2020 года пришлось «с большим беспокойством и печалью» в очередной раз наблюдать за ежегодным факельным шествием в день рождения Степана Бандеры, вместе с Израилем снова выражая Киеву протест против чествования «фигур, которые нужно раз и навсегда осудить». Обычным явлением на бандеровской Украине стало осквернение памятников мирным полякам и евреям, ставшим жертвами немецких и украинских националистов в период нацистской оккупации.
Для России постмайданное руководство Украины создает такое количество проблем, что можно перечислять их до самой ночи. Причем речь идет не о досадных недоразумениях и трудностях, которые можно было бы преодолевать путем переговоров, а о враждебной политике, сознательно и последовательно проводимой Киевом в отношении Москвы.
Однако современная Украина представляет для нашего общего континента серьезную опасность, выходящую далеко за рамки уже привычных для ее соседей идеологических провокаций и отдельных проявлений агрессии. Рискованные эксперименты Киева с размещением на подконтрольной ему территории биологических лабораторий ставят под угрозу эпидемиологическую безопасность всей Европы и вызывают обоснованное беспокойство в Азии.
В настоящее время на территории Украины, по разным данным, насчитывается около полутора десятков биолабораторий, финансируемых министерством обороны США. Возникает закономерный вопрос: а что, собственно, забыл Пентагон в столь далекой от Америки стране? Почему армии США вдруг понадобилось тратить миллионы долларов американских налогоплательщиков на создание такой обширной сети военных объектов, работающих со штаммами смертельных заболеваний, которые могут использоваться в качестве биологического оружия?
Несмотря на то что биолаборатории США появились на территории Украины 15 лет назад, необходимой верифицируемой информации относительно их реального предназначения и практического использования нет до сих пор. В ответ на обращение лидера парламентской партии «Оппозиционная платформа — За жизнь» Виктора Медведчука посольство США признало лишь сам факт наличия и финансирования американцами соответствующих объектов, якобы созданных для того, «чтобы всем нам жилось безопаснее». Причем с украиноязычной версии сайта диппредставительства почему-то уже исчезла опубликованная в 2017 году информация о проведении исследований с использованием «особо опасных» «человеческих патогенов» как минимум в одной из «лабораторий 3-го уровня биологической безопасности».
Даже если вдруг предположить, что предназначение военных объектов американцев на территории Украины и других стран постсоветского пространства сугубо мирное, безвредность работающих со смертоносными штаммами лабораторий вызывает обоснованные сомнения. «Нежелание Вашингтона обеспечивать транспарентность своей военно-биологической деятельности в различных регионах мира, конечно, наводит на вопросы о том, что на самом деле происходит и какие цели преследуются», — отметил недавно глава российского внешнеполитического ведомства Сергей Лавров.
Позицию руководства России, уже не первый год выступающего за создание международных верификационных механизмов с целью недопущения производства и распространения биологического и токсинного оружия, сегодня активно лоббируют и китайские дипломаты. В конце апреля официальный представитель МИД КНР Гэн Шуан призвал США учесть обеспокоенность мирового сообщества и озаботиться «сохранением жизни и здоровья населения», проживающего вблизи объектов повышенной биологической опасности.
Важно отметить, что американские военные лаборатории достаточно плотно формируются именно по периметру российских границ и вблизи Китая. Более того, дополнительную обеспокоенность вызывает расположение биологически опасных объектов в крупных городах или в непосредственной близости от них (Одесса, Харьков), рядом с аэропортами (Тбилиси) или в сейсмоопасных зонах (Ереван, Гюмри, Алма-Ата).
Даже на территории США американские центры по контролю и профилактике заболеваний (CDC) были вынуждены признать как минимум пять чрезвычайных происшествий с опасными биоматериалами в период с 2004 по 2014 год. Высокопрофессиональные специалисты вопреки инструкциям забывали деактивировать бактерии сибирской язвы, случайно смешивали высокопатогенный и «обычный» штаммы птичьего гриппа и перепутывали образцы возбудителей бруцеллеза с вакциной от этой болезни.
Летом 2019 года из-за несоблюдения стандартов биологической безопасности CDC на несколько месяцев приостанавливали деятельность медицинского Научно-исследовательского института инфекционных болезней армии США (USAMRIID), экспериментирующего с самыми опасными в мире патогенами. Кэрол Кримм, депутат палаты делегатов штата Мэриленд, в котором размещается указанное учреждение, выразила обеспокоенность тем, что никто так и не счел необходимым проинформировать местных жителей о конкретных причинах временного закрытия института.
Если даже в самих Соединенных Штатах Америки армейские структуры могут позволить себе такую откровенную нетранспорентность в работе с возбудителями смертоносных заболеваний, то остается только догадываться, насколько плачевно могут обстоять дела с обеспечением безопасности объектов армии США на территории Украины. Так, например, если верить представленной экс-министром транспорта Евгением Червоненко информации, у одной из биолабораторий, которые по всем нормативам должны быть абсолютно изолированы от окружающей территории и людей, «вентиляция выходит в детский сад».
На этом фоне совершенно иначе воспринимается накопленный массив информации о вспышках «атипичных» опасных заболеваний, зафиксированных на Украине за годы существования американских биологически опасных объектов. В 2009 году 450 человек стали жертвами распространившейся из тернопольского вирусного очага геморрагической пневмонии. В 2011, 2014 и 2015 годах в Николаеве и других городах страны отмечена вспышка холеры. В январе 2016 года как минимум 20 военнослужащих в Харькове навсегда выбыли из строя из-за похожего на грипп вируса. Спустя два месяца 364 жителя разных регионов Украины скончались от свиного гриппа A (H1N1)pdm09. В 2017 году в Николаеве, Харькове, Одессе и Запорожье зафиксирована вспышка гепатита А.
Сегодня едва ли можно с достаточной уверенностью сделать вывод о том, что столь частые эпидемии редких заболеваний связаны с функционированием на территории Украины американских биологически опасных объектов. Однако тем более нельзя безапелляционно утверждать, что «этого не может быть, потому что этого не может быть никогда». Почему США с 2001 года практически в одиночку подрывают усилия России, КНР и других стран по подготовке дополнительного протокола к Конвенции о запрещении разработки, производства и накопления запасов бактериологического (биологического) и токсинного оружия и об их уничтожении (КБТО)? Ведь продвигаемый Москвой и Пекином универсальный верификационный механизм предоставил бы американцам возможность продемонстрировать всему миру, что им нечего скрывать. А стало быть, и странам, вблизи или на территории которых функционируют биолаборатории США, нечего опасаться.
Представители китайского экспертного сообщества отмечают растущую необходимость в скорейшем рассмотрении проблематики глобального противодействия производству и распространению биологического оружия и его компонентов на уровне Совета Безопасности ООН. Чем более консолидированное давление в этом принципиальном вопросе будет оказано мировым сообществом на США, тем больше шансов не допустить реализации неблагоприятных эпидемиологических сценариев вблизи российских и китайских границ. В противном случае Украина, равно как и другие «приютившие» на своей территории американские биолаборатории страны, рискует стать для самой себя и государств-соседей биологически опасной миной замедленного действия. Со всеми вытекающими последствиями…
Автор — руководитель аналитического центра «СтратегПРО»
Позиция редакции может не совпадать с мнением автора